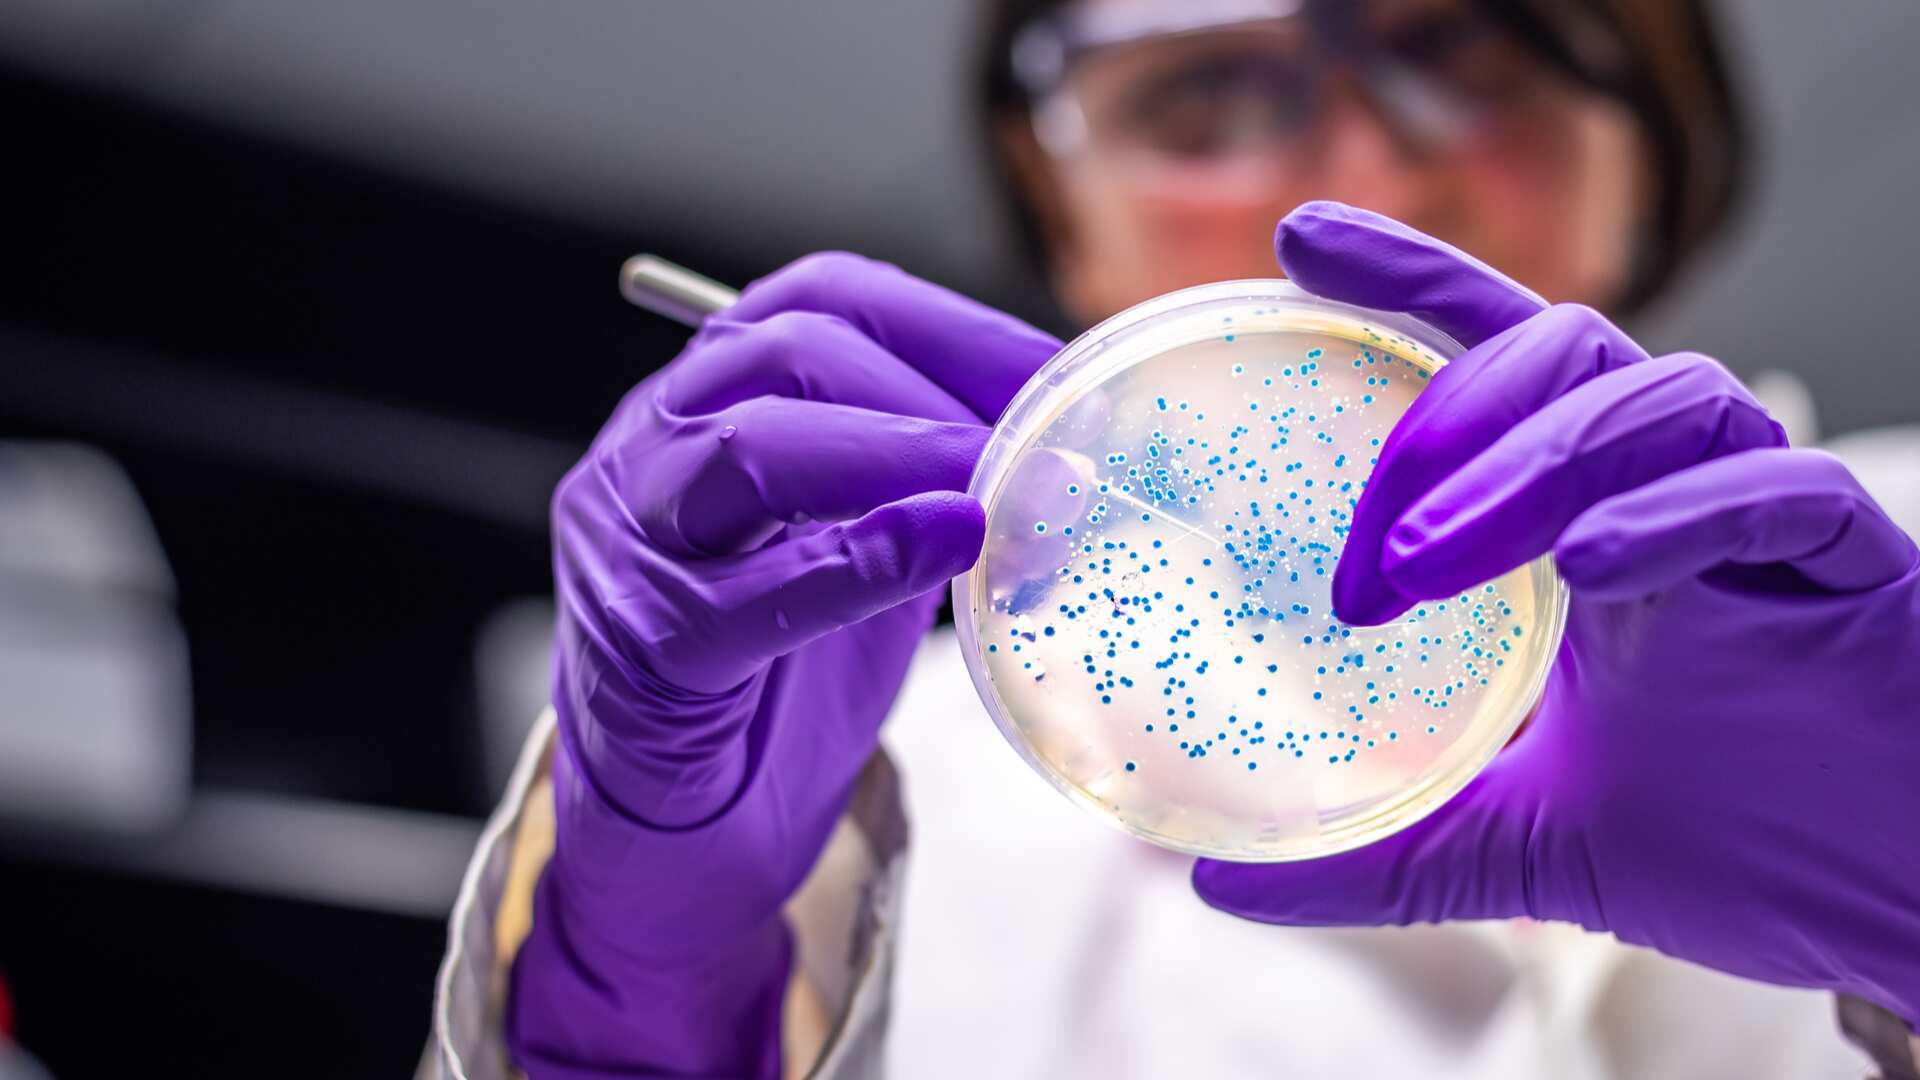

El nuevo reporte de casos de contagiados de coronavirus en el país ya fue emitido por el Ministerio de Salud. Nuevos casos de coronavirus en Colombia hoy 18 de agosto
Son 3.154 nuevos casos registrados para este miércoles 18 de agosto de 2021. Colombia llega a 4.877.323 contagiados.
Además, se reportan 93 nuevos fallecidos para un total de 123.781 muertos por el virus. Un total de 4.702.478 pacientes recuperados en todo el país.
Estos son los conglomerados en el país. Los territorios son: Amazonas, Antioquia (Ituango), Arauca, Atlántico, Barranquilla, Bogotá, Boyacá, Bolívar, Buenaventura, Caldas, Caquetá, Cartagena, Cauca, Cesar, Chocó, Córdoba, Cundinamarca, Huila, La Guajira, Magdalena, Meta, Nariño, Norte de Santander, Quindío, Risaralda, San Andrés, Santa Marta, Santander, Sucre, Tolima, Valle, Vaupés, Vichada, Guaviare y Guainía.Nuevos casos de coronavirus en Colombia, hoy 18 de agosto.
Nuevos casos de coronavirus en Colombia, hoy 18 de agosto
Con esta cifra, ya son 4.877.323 los casos de contagiados en total en el país.
La información detallada de cada uno de los casos podrá ser consultada en la web dispuesta para este propósito por el Instituto Nacional de Salud:
Esta es la infografía de Minsalud con los nuevos casos de coronavirus en Colombia, hoy 18 de agosto.